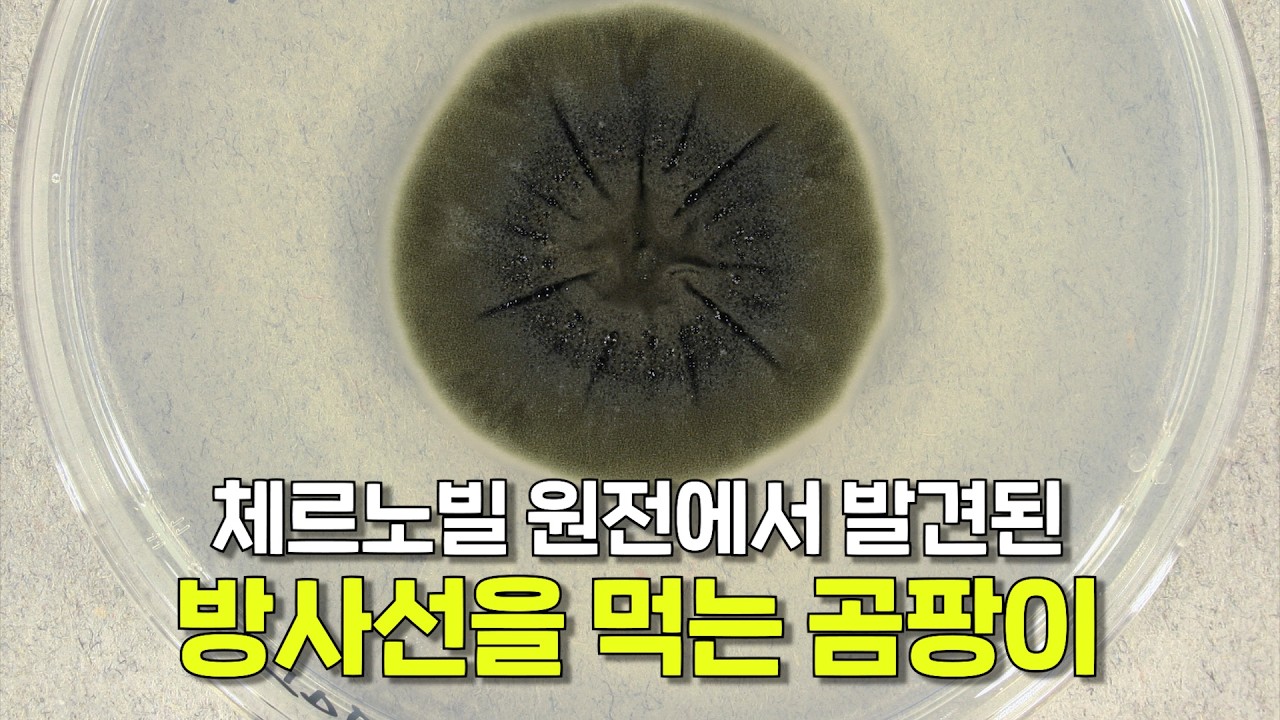
방사선을 먹고 사는 곰팡이가 발견됐다고?

Скачать или смотреть AI로 사주를 볼 때 중요한 점 3가지
-
2026-02-15
-
47901

Скачать AI로 사주를 볼 때 중요한 점 3가지 бесплатно в качестве 4к (2к / 1080p)
У нас вы можете скачать бесплатно AI로 사주를 볼 때 중요한 점 3가지 или посмотреть видео с ютуба в максимальном доступном качестве.
Для скачивания выберите вариант из формы ниже:
-
Информация по загрузке:
Cкачать музыку AI로 사주를 볼 때 중요한 점 3가지 бесплатно в формате MP3:
Если иконки загрузки не отобразились, ПОЖАЛУЙСТА,
НАЖМИТЕ ЗДЕСЬ или обновите страницу
Если у вас возникли трудности с загрузкой, пожалуйста, свяжитесь с нами по контактам, указанным
в нижней части страницы.
Спасибо за использование сервиса video2dn.com

![[커피타임] 신년을 맞아 사주를 봤습니다 - 이진우, 박정호](https://i.ytimg.com/vi/4iLXiddu1NA/maxresdefault.jpg)

![무당에 대한 흥미로운 19가지 사실?! 진짜인지 거짓인지 현직 무당이 알려드립니다! [유민지의 공포라디오]](https://i.ytimg.com/vi/TbdvZQkT-wg/maxresdefault.jpg)









![[명지쌤의 뿌리 인문학] 부자 사주 | 내 사주는 수생목생화 되는가](https://i.ytimg.com/vi/FIs2IirEDcQ/maxresdefault.jpg)

![[사주] 천을귀인처럼 좋은 신살이 잘 발현되는 사람들은 따로 있습니다ㅣ있으면 좋은 길살 모음집😇](https://i.ytimg.com/vi/LTnuvjiwvLY/maxresdefault.jpg)
Информация по комментариям в разработке